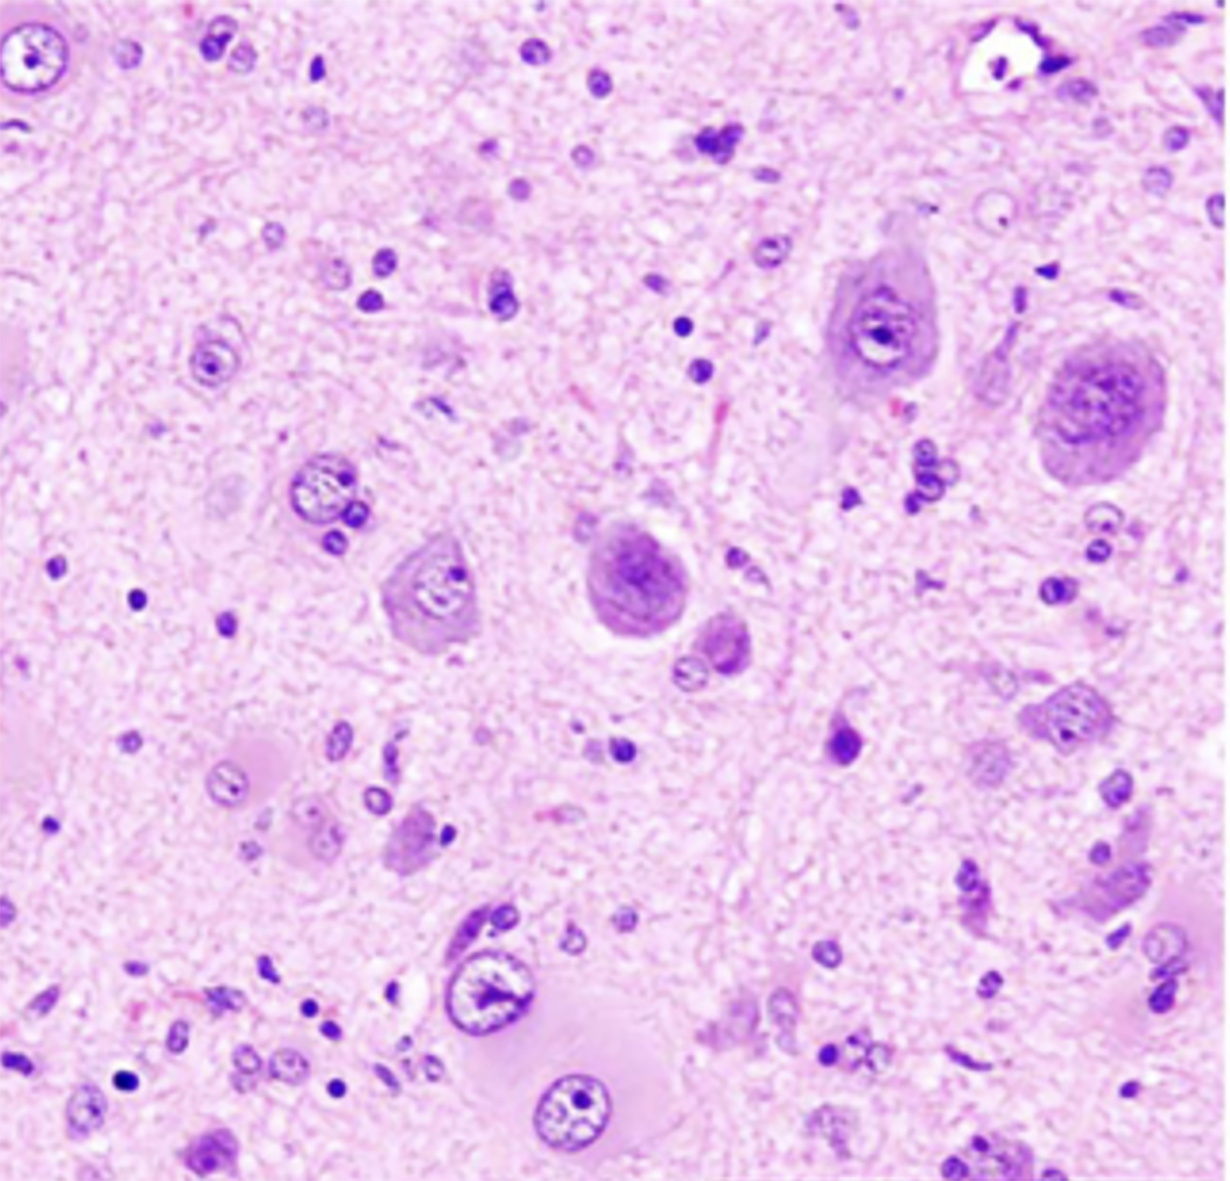

Research Training Group (RTG) 3151
Development and epileptogenesis of dysplasias
in the interplay of distinct CNS cell types
Funded by the German Research Foundation
(Deutsche Forschungsgemeinschaft (DFG))
Apply
Welcome to the RTG 3151 application process.
The current application round is now open!
The application portal closes on February 15, 2026.
Please read this page carefully before applying. If you have further questions about the application process, please refer to our FAQ page.
Our offer
-
- A unique PhD program linking basic neuroscience with clinically relevant neurodevelopmental and epilepsy research. You can become an expert in integrating research on neuronal network structure and function with neurovascular biology, neuroimmunology and disruptive therapy concepts including phototherapies and CRISPRa/i.
- A unique, multidisciplinary research concept and state-of-the-art infrastructure.
- Competitive salary for the whole duration of your studies (approx. monthly net salary around 1800 EUR, increasing over the years) (corresponding to approx. 65% of the remuneration group 13 of the TVÖD Bund / TVÖD Land).
- Clinical rotation to provide a contextual framework of your research.
- A multitude of training opportunities: specialized methods workshops, soft skill and writing courses, travel grants, soft skills courses peer learning, etc..
- Mentoring and guidance by a Thesis Advisory Committee.
- Career development coaching.
- Active participation in ‚public and patient involvement‘ and public outreach
- Administrative local and international support with a dedicated Coordination Office.
- Family support.
Your application requirements
You are invited to apply if you meet the following requirements:
- Strong interest in pursuing a PhD in Developmental Neurobiology
- Master’s degree (or equivalent) in a relevant field [Master degree needs to be awarded before September 2026]
- Fluency in written and spoken English
Note: The right to confer degrees remains with the University of Bonn and you must meet all the admission and degree requirements of the faculty where you choose to study. You can check the regulations here:
- PhD Neuroscience: Medical Faculty PhD Office
- Dr. rer. nat.: Mathematics & Natural Sciences PhD Office
Your application preparation
- Prepare your documents: You will need to provide your Bachelor’s certificate and transcript. If you have already completed a Master’s degree, you will also need to include your Master’s certificate and transcript. If your academic records are not in English, you must submit translations along with the original documents. At the online application stage, unofficial translations are sufficient. However, if you are accepted into the program, you will be required to provide official translations into English.
- Prepare your motivation letter: Your motivation letter should be addressed to the Selection Symposium. It should clearly explain why you are applying to the RTG 3151 program specifically. Why is this program the right fit for you? Why are you a good fit for the program? Highlight any relevant practical experience and skills you have already gained that will prepare you for a successful PhD.
- Learn about our faculty and select three Participating Researchers (PRs) Please read about our faculty members and identify three Participating Researchers whose research interests you most. In your research statements, explain why you would like to pursue your PhD in each of these labs. The research statements will be read by the Selection Committee (comprising the PRs), so they should be written in a general format—not addressed to individual PRs. Which research questions fascinate you? What kind of research would you like to pursue in each of these labs? Please note: If you successfully pass the Selection Symposium, you can select a PI among all hiring faculty members: the choice you make during the application process is not binding.
- Identify two referees:Please contact your potential referees early – ideally before you start the application process. Choose your referees carefully and ensure they are able to submit their letters before the deadline. Reference letters must be uploaded directly by the referees; applicants cannot upload or view these letters themselves.
Your application
- The application round is open. This is when the application portal will open and you can create an account.
- You can click “Create new account” to register and work on your application.
- Fill out the Online Application.
- You will be asked to name two referees in the application. Inform them early and ask them to follow the instructions at the link we send them.
- You will be informed when your referees upload the letters. Your application is NOT complete without the letters of recommendation!
- After the deadline, the Selection Committee will review all complete applications.
- Successful applicants will be invited to an online
selection symposium
on March 19 and 20, 2026. Applicants who did not get shortlisted will be notified by beginning of March. - All candidates who passed the Selection Symposium will be invited to Bonn for individual interviews, lab tours and to meet the lab and team members as well as current PhD students in the PR labs. Dates will depend on visa requirements, travel will be supported by the RTG 3151.
- Accepted candidates should plan to start their PhD on September 1, 2026.
